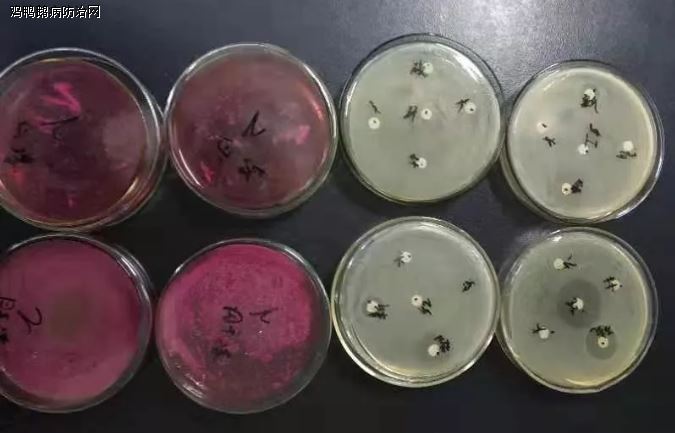
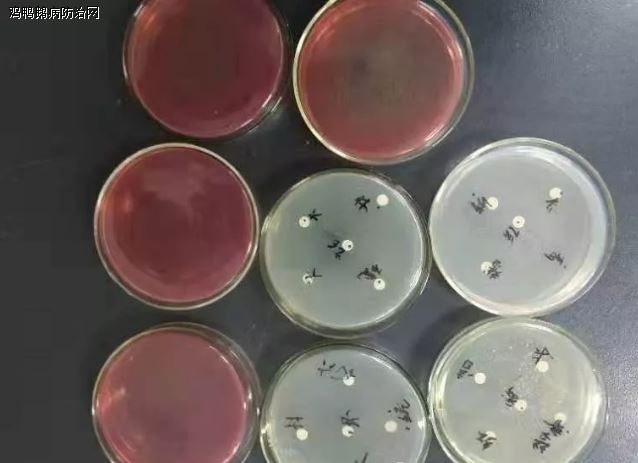

鸡鸭鹅病防治网联合驰骋中兽医研究所共同分享:
星期日,早上接到《鸡鸭鹅病防治网》魏黎明打来了电话,山东菏泽孙老师发来18天肉鸭病例,解剖其他不明显,有神经症状,我急急忙忙赶到禽病化验室。
送来了两只18日龄的樱桃谷肉鸭,冷藏保存,解剖明显有纤维素渗出,包心包肝症状,实验室细菌分离,明显有大肠杆菌,不排除鸭浆膜炎症状,为了能够让大家更好的区分这两个病,简单叙述一下这两个病的特点。
鸭传染性浆膜炎
病原:
鸭浆膜炎是由鸭疫里氏杆菌引起的一种败血性疾病。
临床症状:
该病大多发生在7-20日龄,发病时精神沉郁,拉白色稀便或不成形的稀绿便。个别的鸭子会出现头颈歪斜、软脚、缩颈、拱背,站不起来或瘫痪等症状,平时在鸭群中赶鸭向前走时,出现落队现象等,若严重时可出现零星的死亡等,这都是浆膜炎的症状。
剖检变化:
在心脏、肝脏上将不同程度包有白色或黄色的干酪样分泌物。
治疗方案:
驰骋好得快饮水,300-400斤/瓶+驰骋芪贞颗粒+新力爽饮水 ,严重时建议以上三种药各一瓶一包混合兑水300斤,集中饮水3-4个小时(要做到每只鸭子都饮到药水)。
浆膜炎的治疗原则是:
“准、很、快”,早发现早治疗,发现一例,全群注射,大群足量投服药物,同时注意保肝护肾。
预防方案:
鸭苗接回家,1-5日龄同时驰骋芪贞颗粒+好得快饮水,效果奇佳。
鸭大肠杆菌病
病原:
大肠杆菌。
临床症状:
大肠杆菌病多发于20日龄以后,鸭群中有耸脖、走路摆尾,排不成形黄色、白色的粪便。
剖检变化:
可见到“包心、包肝”现象,并闻到一股腥臭味,有时可见到腹腔中黄色干酪样的分泌物,这是与浆膜炎主要区别之处。
治疗方案:
驰骋好得快饮水,300-400斤/瓶或驰骋芪贞颗粒+新力爽饮水,鸭大肠杆菌病,要早发现早治疗。若该发病时间较长,治疗时要加些抗病毒及提高抵抗力的药,如清瘟败毒散、黄芪多糖粉等。
预防方案:
同鸭浆膜炎,更要注意环境卫生,特别是垫料要干燥,防止霉变,加强通风防止有害气体超标。
总结与分析:
鸭浆膜炎与大肠杆菌的区别诊断:
A、从发病日龄上,浆膜炎的发病多在20日龄以前,而大肠杆菌病在20日龄以后多见。
B、剖检时,大肠杆菌病可闻到坏鸡蛋的醒臭味,而浆膜炎基本没味或很小。

农历二月初一,明天龙抬头,今日提醒:最近鸭子疫情高发,大家多注意观察,要做到早发现,早治疗,不要延误病情! 鸡鸭鹅病防治网 成龙在路上提醒大家 13838248089. 魏老师在线指导 13939027068.
进入春天,春暖花开、阳气上升、疫病多发,早晚温差大,养殖朋友们注意防寒保暖、舍内通风,产蛋率下降的很多,部分出现采食量下降,只要不是持续出现下降,大家不要着急,可以等温度正常后,根据实际情况做出相应调整方案!
水禽疫病临床解决专家--魏老师(13939027068)建议朋友们:一定要在饲料中添加养殖安,饮水中添加驰骋EAD乳液+驰骋芪贞颗粒,即可减少疾病、促进消化、增强抗病能力、提升免疫力、产蛋率稳定! 鸡鸭鹅病防治网 www.jyebfz.com 成龙在路上提醒大家 138-3824-8089. 建议增蛋方案:养殖安+驰骋EAD乳液,一定要定期使用,每月2次,每次5-7天! 经销商朋友一定要学会使用、推广!近几天走访多家鸭老板与种鸭、蛋鸭场60多家,种鹅场20余家。病症很多:主要是采食量下降、产蛋率低、零星死亡、脱肛、掉毛等情况,在驰骋水禽与家禽营养保健与疫病防控研究所--魏老师(13939027068)指导下,提出有效解决方案,多家养殖场通过使用我们的方案,已经获利颇丰、获益匪浅!






发表评论共有0访客发表了评论
暂无评论,快来抢沙发吧!